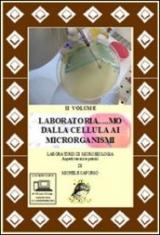

Ricerca la tua scuola
Utilizza la griglia sottostante per cercare la tua scuola ed avere una lista dei libri adottati dalla tua classe quest'anno.
Libri da Acquistare
CHIMICA
ZANICHELLI EDITORE
Prezzo: € 45,00
ISBN: 9788808662613
Elementi di chimica analitica strumentale. Tecniche di analisi per biotecnologie ambientali e sanitarie. Con espansione online
di Cozzi Renato, Protti Pierpaolo, Ruaro TarcisioZANICHELLI EDITORE
Prezzo: € 45,00
ISBN: 9788808662613
LINGUA E LETTERATURA ITALIANA
B.MONDADORI
Prezzo: € 38,80
ISBN: 9788869105265
Scoprirai leggendo. Letteratura italiana. Con e-book. Con espansione online. Vol. 2
di Di Sacco Paolo, Manfredi PaolaB.MONDADORI
Prezzo: € 38,80
ISBN: 9788869105265
Al momento non disponibile, ordinabile in 3 settimane circa
Ordina libro
Aggiungi a lista dei desideri
LINGUA INGLESE
OXFORD UNIVERSITY PRESS
Prezzo: € 44,10
ISBN: 9780194038973
ENGL FILE 4E DIGITAL GOLD B1+/B2 SB/WB WITHOUT KEY + ECHK + EBK
di AA VVOXFORD UNIVERSITY PRESS
Prezzo: € 44,10
ISBN: 9780194038973
Al momento non disponibile, ordinabile in 3 settimane circa
Ordina libro
Aggiungi a lista dei desideri
STORIA
LA SCUOLA EDITRICE
Prezzo: € 25,50
ISBN: 9788835047681
Guida allo studio della storia. Verso l'interrogazione. Per le Scuole superiori. Con e-book. Con espansione onlie
diLA SCUOLA EDITRICE
Prezzo: € 25,50
ISBN: 9788835047681
MATEMATICA
ZANICHELLI EDITORE
Prezzo: € 44,30
ISBN: 9788808928702
Matematica.verde. Con Tutor. Per le Scuole superiori. Con e-book. Con espansione online vol.4A-4B
di Massimo Bergamini, Graziella Barozzi, Anna TrifoneZANICHELLI EDITORE
Prezzo: € 44,30
ISBN: 9788808928702
SCIENZE NATURALI (BIOLOGIA, CHIMICA, SCIENZE DELLA TERRA)
MANNARINO EDITORE
Prezzo: € 12,00
ISBN: 9788890255427
Laboratoria... mo dalla cellula ai microrganismi. Laboratorio di microbiologia. Aspetti teorici e pratici. Con espansione online. Con DVD-RO. Vol. 2
di Capurso MicheleMANNARINO EDITORE
Prezzo: € 12,00
ISBN: 9788890255427
ANATOMIA FISIOLOGIA IGIENE
SIMONE PER LA SCUOLA
Prezzo: € 21,00
ISBN: 9788891434739
Igiene anatomia fisiologia patologia. Per il 2° anno degli Ist. tecnici. Con e-book. Con espansione online vol.2
di Amedeo GiammarinoSIMONE PER LA SCUOLA
Prezzo: € 21,00
ISBN: 9788891434739
Al momento non disponibile, ordinabile in 3 settimane circa
Ordina libro
Aggiungi a lista dei desideri
BIOLOGIA, MICROBIOLOGIA E TECNOLOGIE DI CONTROLLO SANITARIO
ZANICHELLI EDITORE
Prezzo: € 33,30
ISBN: 9788808590763
BIOLOGIA, MICROBIOLOGIA E TECNOLOGIE DI CONTROLLO SANITARIO - VOL. 1 (LD) ND
di FANTI FABIOZANICHELLI EDITORE
Prezzo: € 33,30
ISBN: 9788808590763
Al momento non disponibile, ordinabile in 3 settimane circa
Ordina libro
Aggiungi a lista dei desideri
Libri in uso
CHIMICA
ZANICHELLI EDITORE
Prezzo: € 50,80
ISBN: 9788808620514
Chimica organica. Dal carbonio alle biomolecole. Per le Scuole superiori. Con e-book. Con espansione online
di Hart Harold, Hadad Christopher M., Craine Leslie E., Hart David J.ZANICHELLI EDITORE
Prezzo: € 50,80
ISBN: 9788808620514
LINGUA INGLESE
OXFORD UNIVERSITY PRESS
Prezzo: € 33,50
ISBN: 9780194189781
FINISH FIRST B2 SB&WB + EXAM TRAINER + DIGITAL PACK (EBOOK + ONLINE PRACTICE + 15 EREADERS +
di AA VVOXFORD UNIVERSITY PRESS
Prezzo: € 33,50
ISBN: 9780194189781
Al momento non disponibile, ordinabile in 3 settimane circa
Ordina libro
Aggiungi a lista dei desideri
LINGUA INGLESE
EDISCO
Prezzo: € 27,40
ISBN: 9788844121761
A MATTER OF LIFE, 4TH EDITION ENGLISH FOR CHEMISTRY, BIOLOGY AND BIOTECHNOLOGY
di BRIANO PAOLA - ANERDI MARIA GRAZIAEDISCO
Prezzo: € 27,40
ISBN: 9788844121761
Al momento non disponibile, ordinabile in 3 settimane circa
Ordina libro
Aggiungi a lista dei desideri
SCIENZE MOTORIE E SPORTIVE
D'ANNA
Prezzo: € 24,50
ISBN: 9788857790848
Il corpo e i suoi linguaggi. La palestra del benessere. Logica in gioco. Ediz. verde. Per le Scuole superiori. Con e-book. Con espansione online. Con DVD-ROM
di Del Nista P. Luigi, Tasselli AndreaD'ANNA
Prezzo: € 24,50
ISBN: 9788857790848
RELIGIONE CATTOLICA/ATTIVITA' ALTERNATIVA
LA SCUOLA EDITRICE
Prezzo: € 18,90
ISBN: 9788835047537
Il nuovo tiberiade. Le grandi religioni. Per le Scuole superiori. Con e-book. Con espansione online
di Manganotti Renato, Incampo NicolaLA SCUOLA EDITRICE
Prezzo: € 18,90
ISBN: 9788835047537